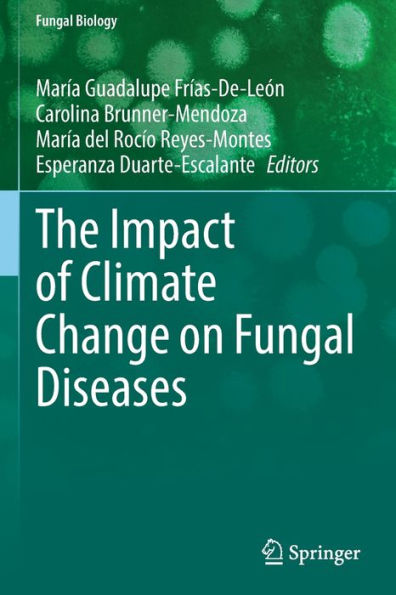

1
/
of
1
Springer
The Impact Of Climate Change On Fungal Diseases (Fungal Biology) - 9783030896669
The Impact Of Climate Change On Fungal Diseases (Fungal Biology) - 9783030896669
ISBN-13: 9783030896669
Regular price
$180.44
Regular price
Sale price
$180.44
Unit price
/
per
Couldn't load pickup availability
The shift of weather patterns has affected the incidence and prevalence of infectious diseases, including mycoses. Mycoses have remained neglected due to a lack of training and recognition within the medical community. Nonetheless, these diseases remain common worldwide while frequently being underdiagnosed. Climate change affects the distribution of fungal communities, provoking outbreaks in locations where these mycoses were absent or in low frequencies. Moreover, the reports of clinical cases related to new fungal pathogens have increased due to the description of new fungal species or due to the ability of some species to shift to new hosts. Thus, this book, The Impact of Climate Change on Fungal Diseases, is a contribution to the knowledge of a global environmental phenomenon and its relation to these diseases, and it serves as a guide for health professionals to dive deep into the repercussions of climate change and how they can implement measures for the prevention and control of fungal infections.
- | Author: María Guadalupe Frías-De-León, Carolina Brunner-Mendoza, María Del Rocío Reyes-Montes, Esperanza Duarte-Escalante
- | Publisher: Springer
- | Publication Date: Mar 09, 2023
- | Number of Pages: 320 pages
- | Language: English
- | Binding: Paperback
- | ISBN-10: 3030896668
- | ISBN-13: 9783030896669
Share